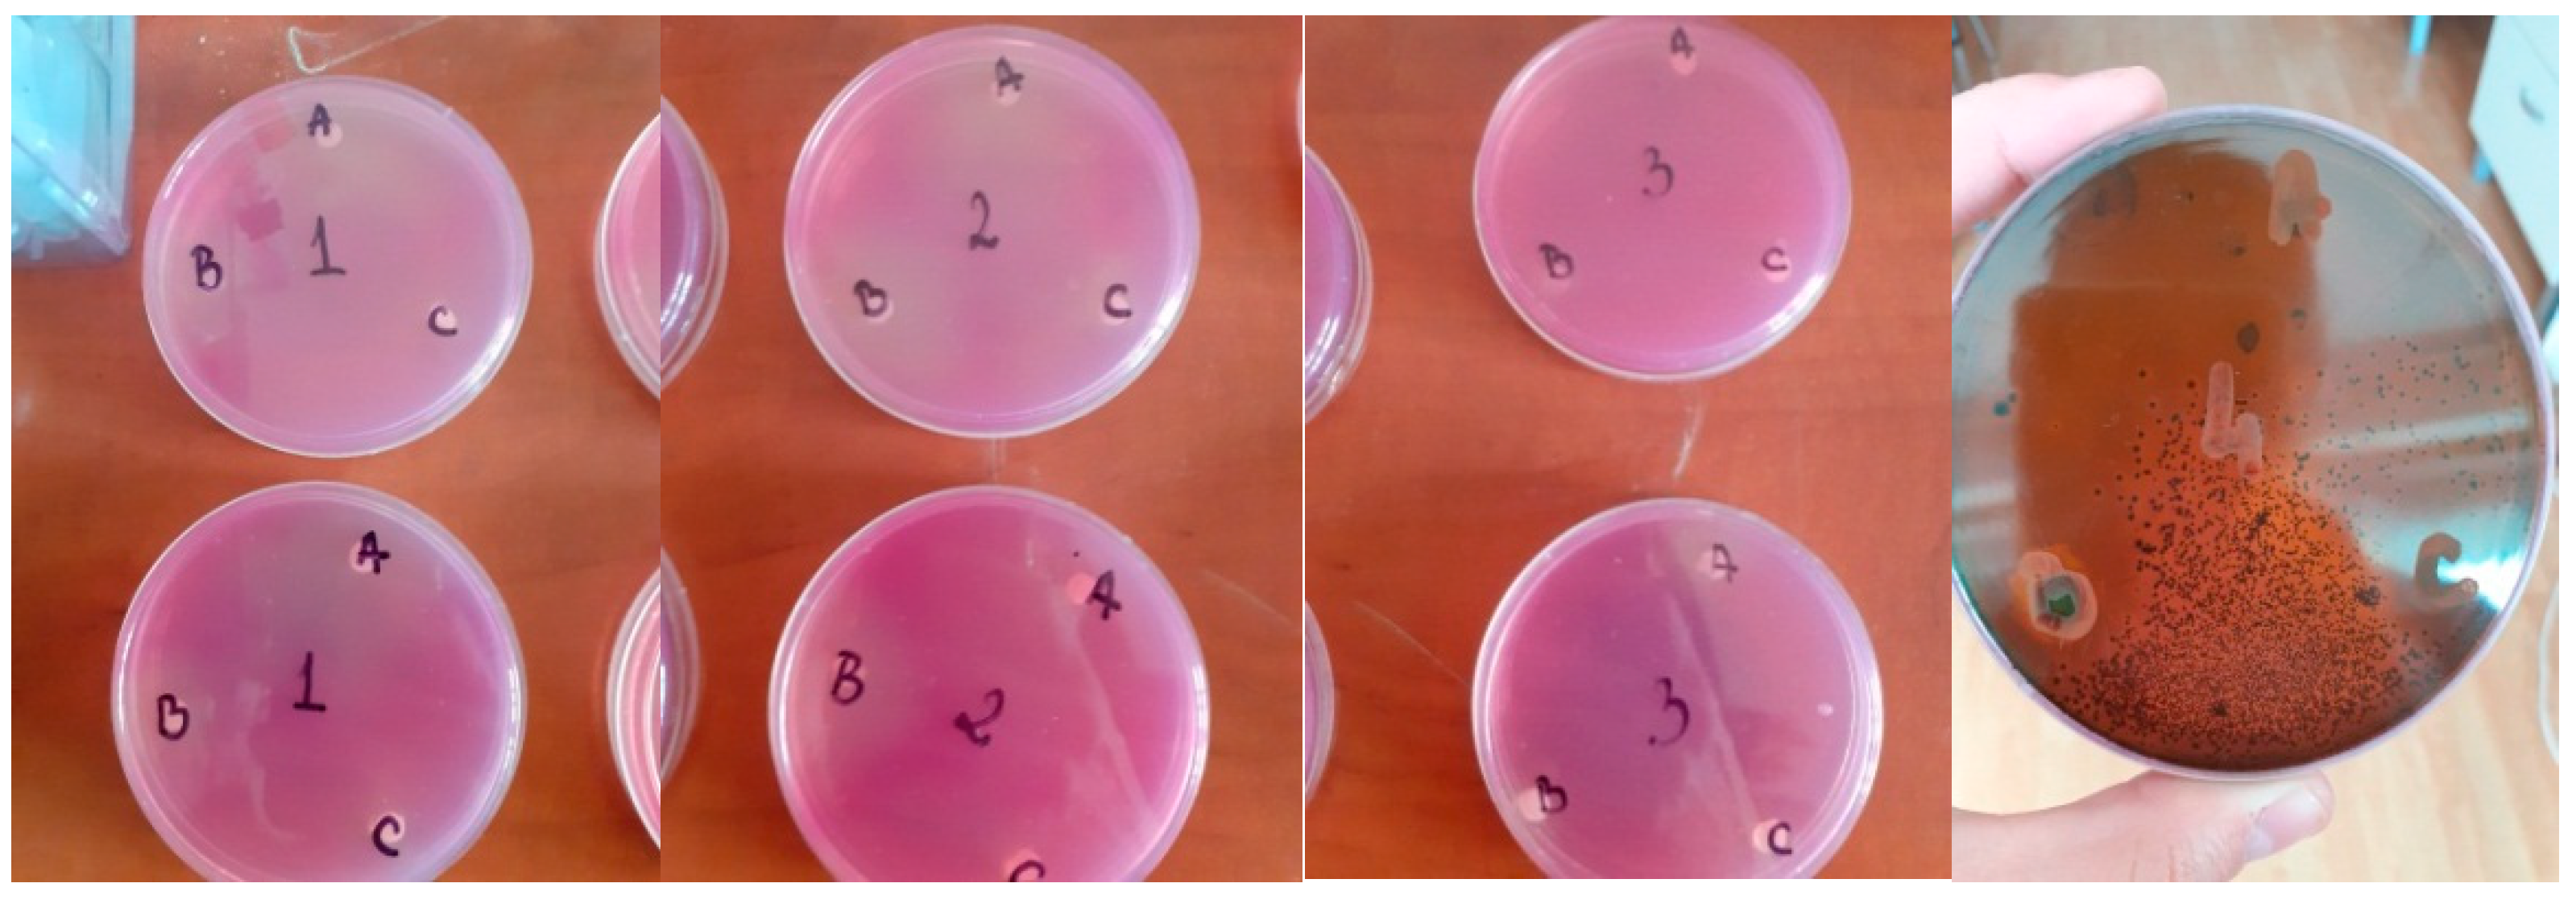
Applsci 13 02993 g001

1. Introduction
Dairy products contain a large number of proteins and are an important source of exogenous amino acids that influence metabolic processes and bring important benefits to the consumer’s health [
1]. There is an increased interest in producing fermented milk drinks with nutritional properties which benefit consumers’ health [
2]. Kefir has an acid-alcoholic taste [
3] produced as a result of acid and alcoholic fermentation [
4,
5]. The fermentation process plays an important role because the volume of calcium, vitamins, and amino acids increases [
6,
7]. Following the studies carried out, it was concluded that kefir contains numerous substances beneficial to health that have antioxidant, antimicrobial, and anti-inflammatory properties [
8,
9,
10,
11,
12]. In addition, kefir consumption lowers the risk of cardiovascular disease by attenuating the increase in protein C [
13].
Current research is mainly based on functional foods that contain plant derivatives with antioxidant, antimicrobial, anticancer, and anti-inflammatory properties [
14,
15].
Traditional uses for lavender (
Lavandula angustifolia Mill.) include culinary use, treatment of burns and skin wounds, and relief from headaches and digestive problems [
16]. Moreover, lavender has antioxidant, antimicrobial, antispasmodic, antidepressant, analgesic, and carminative properties for various diseases [
17,
18]. Numerous antibacterial, antioxidant, and insecticidal activities are present in lavender volatile oil [
16,
19]. The most important constituents of the volatile lavender oil are 1,5-Dimethyl-1-vinyl-4-hexenyl butyrate [
17], camphor, cineole, terpineol, and borneol [
20]. The antimicrobial properties of lavender and lavender volatile oil have been studied by various researchers in recent years. The capacity of volatile lavender oil to prevent
Listeria innocua (Gram-positive) was shown in the study by Marn et al. in 2016 [
21]. In 2021, Benbrahim et al. showed that volatile lavender oil has antibacterial properties against antibiotic-resistant strains of
Klebsiella pneumoniae without cytotoxicity on human lymphocytes [
22].
Mint (
Mentha piperita L.) is used in gastronomy but also in the pharmaceutical and cosmetic industry [
23,
24]. The volatile mint oil contains phenols and flavonoids, which have antioxidant and antibacterial effects. It is typically used to treat a variety of digestive illnesses, including diarrhea, intestinal inflammation, and nervous system issues [
24,
25]. Numerous studies have shown that volatile mint oil can combat a wide range of germs, including
Staphylococcus epidermidis,
Escherichia coli,
Staphylococcus aureus,
Enterococcus faecalis,
Bacillus cereus, and
Cronobacter sakazakii [
23]. In 2013, Tsai et al. showed that volatile mint oil contains menthol, alcohol, and terpenes, these compounds giving it an antimicrobial character against
Escherichia coli,
Pseudomonas aeruginosa, and
Staphylococcus aureus [
26]. In 2019, Park et al. established the antimicrobial propriety of volatile mint oil due to its high menthol content [
27]. According to Kapp et al. in 2020, the antibacterial action of mint flavoring in sweets and food supplements against
Staphylococcus aureus and
Escherichia coli may also help to avoid bacterial illnesses and lessen food contamination [
28].
Fennel (
Foeniculum vulgare L.) is an aromatic and therapeutic plant [
29] with anti-inflammatory, analgesic, diuretic, and carminative properties [
30,
31,
32]. In recent years, the real interest has begun to be given to volatile fennel oil obtained from its seeds [
31]. Volatile fennel oil has a hepatoprotective, anti-inflammatory [
30], antioxidant, antimicrobial [
33], and antifungal character [
29]. The flavonoids, phenolic compounds [
32], phenylpropanoid derivatives, and monoterpenoids [
30], as well as trans-anethole, fenchone, estragole, and a-phellandrene, are the most significant components of volatile fennel oil [
34]. Numerous research has shown that volatile fennel oil has antibacterial properties. Anwar et al. in 2009 used the disk diffusion method to show that volatile fennel oil has antibacterial properties against
Bacillus subtilis,
Aspergillus niger, and
Escherichia coli [
31]. In 2019, using the same method, Marín et al. demonstrated the antimicrobial character of this oil on
Listeria innocua (Gram-positive) and
Pseudomonas fluorescens [
21]. Other studies carried out in 2011, 2018, and 2021 demonstrated the antimicrobial character by associating this with the components of volatile fennel oil [
33,
35,
36].
The purpose of our research is to create functional foods that bring nutritional benefits to the consumer by incorporating bioactive components. In 2019, we started studying dairy products enriched with different volatile oils [
37]. This research has been certified by articles, and the positive results obtained have led us to analyze as many compounds in these products as possible. For the present study, we have chosen to continue the studies carried out for kefir enriched with encapsulated volatile oils. The sensory, textural acceptability, and antioxidant capacity of the products were studied, and the results were published in 2022 [
38,
39].
In this context, the present study was designed to determine the changes in the chemical composition of kefir enriched with encapsulated volatile oils by enzymatic methods and the antimicrobial activity of volatile oils.
Enzyme kits from the R-Biopharm company were used. Enzyme analysis is an excellent way to identify numerous compounds in dairy products because the test kits include selected, multi-tested reagents. For the current study, we decided to use these test kits because they have many advantages, the most important being the high degree of safety. These kits are recommended by the IDF (International Dairy Federation) [
40]. The analyzed compounds were lactose, D-glucose, D-galactose, acetic acid, ethanol, L-lactic acid, and L-glutamic acid. The use of volatile oils with antimicrobial capacity aims to increase the finished product’s shelf life. So, using encapsulated volatile oils and cow’s milk, we created three different forms of kefir. Lavender, mint, and fennel were the volatile oils that were utilized.
The antimicrobial capacity of the volatile oils used was tested on several types of microorganisms that poison food products, especially dairy products. Three types of molds (Geotrichum candidum, Penicillium expansum, Aspergillus niger) and one Gram-negative bacterium (Escherichia coli) were selected.
Geotrichum candidum, the best-known species in the genus, is a yeast-like fungus tolerant of acidic environments. Its taxonomic position was revised in 2004 by De Hoog and Smith, the genus
Geotrichum being composed of 22 species [
41].
Geotrichum candidum thrives at temperatures between 5 and 38 °C, with an optimum temperature of 25 °C. It is tolerant to a wide range of pH values, with optimum values between 5.0 and 5.5. It has a low salt tolerance. Unlike yeasts, the growth of
G. candidum is limited by the amount of salt. Concentrations of 1% NaCl lead to slight growth suppression. NaCl concentrations of 5–6% have an inhibitory effect [
42].
Blue mold disease caused by
Penicillium expansum is the most economically important post-harvest disease of stored fruit and vegetables. In addition to causing food spoilage, some strains of the fungus produce patulin mycotoxin [
43]. Patulin is a moderately toxic mycotoxin, but according to studies, it has no carcinogenic or mutagenic effect.
Penicillium species have a highly evolved physiology, resulting in adaptation to a very wide range of habitats. All
Penicillium species can grow in food at a low pH of between 2 and 3. Most
Penicillium species grow at lower temperatures, and none are thermophilic [
44].
Aspergillus niger is a type of mold that causes “black mold” on the outside of certain foods, such as apricots, onions, and grapes [
45].
Aspergillus niger is the most common species of
Aspergillus and is more prevalent in warmer climates, both in field situations and in stored food. Black spores protect against sunlight and UV radiation, giving a competitive advantage in such habitats.
A. niger is very commonly isolated from sun-dried products such as grapes, where it can produce ochratoxin A [
46]. High temperatures and high relative humidity favor the growth of these organisms. The most favorable temperature is 25–40 °C. At temperatures below 15 °C, there is no significant growth, and under refrigerated conditions, there is no growth at all [
47].
Escherichia coli is a member of the family
Enterobacteriaceae, which are facultatively anaerobic Gram-negative rods (possessing both fermentative and respiratory metabolism) and do not produce the enzyme oxidase [
48].
Escherichia coli are introduced into water bacteriology because it is a useful marker of fecal pollution and thus has become an important marker in food and water hygiene [
49].
Escherichia coli is a bacterium that is carried in the gastrointestinal tract of humans and dairy animals. Milk collected for human consumption can become contaminated with
E. coli directly through animal feces or indirectly through media, equipment, and workers [
50]. The technique used to determine antimicrobial activity was Kirby–Bauer.
Due to the oils’ sensitivity to environmental and technological conditions, the technique of their encapsulation was chosen. To compare the obtained results, we made a control sample of kefir without the addition of volatile oils. The analyses were completed on the first, tenth, and twenty-first days that the samples were stored. All results were statistically processed and correlated using the Pearson correlation.
3. Results
3.1. Determination of Antimicrobial Activity
The reading was performed 24 h and 48 h after incubating. A ruler was used to take the reading while also measuring the disc’s diameter and the resulting zone of inhibition. Two Petri dishes with the three different volatile oil were produced, one for each species of microorganism.
Figure 1 shows the Petri dishes with the analyzed samples. The three types of volatile oils were numbered: A, B, and C. A represents the lavender volatile oil sample, B represents the mint volatile oil sample, and C represents the fennel volatile oil sample. The Petri dishes were seeded with the four microorganisms, and their numbering was as follows: 1 represents the dish seeded with
Geotrichum candidum, 2 represents the dish seeded with
Penicillium expansum, 3 represents the dish seeded with
Aspergillus niger, and 4 represents the dish seeded with
Escherichia coli.
Figure 2 shows the inhibitory action of fennel, lavender, and mint volatile oils against
Penicillium expansum,
Aspergillus niger,
Geotrichum candidum, and
Escherichia coli.
In terms of the inhibitory action against Penicillium expansum for volatile fennel oil, the mean of the zone of inhibition’s diameter is 11.5 ± 0.707 mm after 24 h, and after 48 h, it is 17± 0.707 mm, yielding an intermediate qualification. After the first 24 h, the inhibitory zone’s mean diameter in the case of volatile lavender oil is 11 ± 0 mm, yielding a high qualification. After 48 h, the mean is 14.5 ± 0.707 mm, the qualification being intermediate. In the first 24 h, the volatile mint oil has a mean diameter of the inhibition zone of 24.5 ± 0.707 mm, the qualification obtained being sensitive. After 48 h, the mean is 27 ± 0 mm; the qualification is still sensitive. The highest sensitivity of Penicillium expansum is to the volatile mint oil, being resistant or intermediate to the other two.
Regarding the fennel volatile oil’s ability to inhibit Aspergillus niger, the inhibition zone’s average diameter over the first 24 h was 9.5 ± 0.707 mm, resulting in the qualification of resistance. After 48 h, the inhibitory zone’s mean diameter is 12 ± 0 mm; resistance is therefore qualified. After 24 h, the mean for the volatile oil of lavender is 10.5 ± 0.707 mm, indicating that it is resistant. After 48 h, the mean is 13 ± 0 mm, the qualification obtained being resistant. The volatile mint oil has a mean diameter of the inhibition zone of 10 ± 0 mm in the first 24 h, with the qualifier being resistant. After 48 h, the mean is 12.5 ± 0.707 mm, the qualification obtained being resistant. The inhibitory action increases between 24 and 48 h for all three volatile oils. All three oils indicate Aspergillus niger resistance, with volatile lavender oil producing the greatest results and fennel volatile oil producing the worst.
After 24 h, the fennel volatile oil’s inhibition activity against Geotrichum candidum has a mean diameter of the inhibition zone of 11.5 ± 0.707 mm, falling into the category of being resistant. After 48 h, the mean is 14 ± 0 mm; the qualification is still resistant. The average diameter of the zone of inhibition of volatile lavender oil after 24 h is 11.5 ± 0.707 mm, with the descriptor “resistant.” After 48 h, the mean is 15.5 ± 0.707 mm, the qualification to which it falls being intermediate. For volatile mint oil, the mean after 24 h is 22 ± 0 mm, the qualifier being sensitive. After 48 h, the mean is 24.5 ± 0.707 mm, the qualification is still sensitive. The inhibitory action increases between 24 and 48 h, the highest increase with volatile lavender oil. Among all three types of oils, Geotrichum candidum is only sensitive to mint volatile oil after both 24 and 48 h. Fennel volatile oil has the strongest resistance, and volatile lavender oil becomes resistant after 24 h and intermediate after 48 h.
After 24 h, the mean width of the inhibition zone for the fennel volatile oil’s inhibition action against Escherichia coli is 30.5 ± 0.707 mm, with the qualifier being sensitive. The mean is 39.5 ± 0.707 mm after 48 h, with the qualifying being sensitive. After 24 h, the inhibition zone’s mean diameter for volatile lavender oil is 34.5 ± 0.707 mm, with the descriptor “sensitive.” The mean is 39.5 ± 0.707 mm after 48 h, with the qualifying being sensitive. After 24 h, the mean for the volatile oil of mint is 35.5 ± 0.707 mm, with the descriptor “sensitive”. The mean after 48 h is 40.5 ± 0.707 mm, with sensitive being the qualifier. The inhibitory action of all three varieties of volatile oils increases between 24 and 48 h. Escherichia coli show susceptibility to all three types of volatile oils after 24 and 48 h. The volatile oils of mint and fennel caused the greatest and the least amount of sensitivity, respectively.
3.2. Determination of Lactose Content
Table A1 (
Appendix A) presents the results of determining the lactose content for each kefir sample, as well as the statistical processing of the obtained data. For each kefir sample, three replicates were performed on each day of analysis.
Figure 3 compares the variations in lactose concentration between the control sample and the cow’s milk kefir samples that have been enhanced with encapsulated volatile oils.
Regarding the control sample, the first day of storage produced the highest lactose content value, with a mean of 4.579 ± 0.0006 g/100 g. On day 20, the lowest value of the lactose content was recorded, the mean being 3.682 ± 0.0015 g/100 g. The lactose content in the kefir sample with volatile lavender oil increased on the first day of storage, with a mean of 4.683 ± 0.0017 g/100 g. The 20th day of storage saw the lowest lactose content value, with a mean of 4.581 ± 0.0015 g/100 g. The kefir with volatile mint oil had a mean content of 4.664 ± 0.0012 g/100 g, with the highest value being recorded on the first day of storage. The mean lactose content was 4.567 ± 0.0012 g/100 g on the 20th day of storage, the lowest value recorded. The kefir sample with volatile fennel oil had the greatest lactose concentration on the first day of storage, with a mean of 4.607 ± 0.001 g/100 g. The mean lactose content was 4.506 ± 0.0012 g/100 g on the 20th day of storage, the lowest number recorded.
3.3. Determination of D-Galactose Content
Table A2 (
Appendix A) presents the results of determining the D-galactose content for each kefir sample, as well as the statistical processing of the obtained data. For each kefir sample, three replicates were performed on each day of analysis.
Figure 4 compares the variance in D-galactose content between the control sample and the samples of cow’s milk kefir that has been enhanced with encapsulated volatile oils.
On the first day, the D-galactose level in the control sample was greatest, with a mean of 1.0378 ± 0.0001 g/100 g. The 20th day had the lowest D-galactose level, with a mean of 1.0098 ± 0.0002 g/100 g. With a mean of 1.3021 ± 0.0001 g/100 g, the kefir sample with volatile lavender oil had the greatest D-galactose level on the first day. On the twentieth day, the mean amount of D-galactose was 1.2014 ± 0.0003 g/100 g. The D-galactose content in the kefir sample with volatile mint oil was highest on the first day of storage, and the mean value was 1.1793 ± 0.0001 g/100 g. On day 20 of storage, 1.0856 ± 0.0002 g/100 g was recorded as the lowest D-galactose concentration value. The mean of the D-galactose content from the first day is 1.0848 ± 0.0001 g/100 g for the kefir with volatile fennel oil. The mean D-galactose content is 1.0662 ± 0.0002 g/100 g on the 10th day of storage and 1.0415 ± 0.0001 g/100 g on the 20th day.
3.4. Determination of D-Glucose Content
Table A3 (
Appendix A) presents the results of determining the D-glucose content for each kefir sample, as well as the statistical processing of the obtained data. For each kefir sample, three replicates were performed on each day of analysis.
Figure 5 compares the variations in D-glucose content between the control sample and the kefir samples that have been enhanced with encapsulated volatile oils.
All of the kefir samples see a drop in D-glucose content during the 20-day storage period. On the first day of storage, the control sample has a D-glucose level of 0.0312 ± 0.0001 g/100 g. The mean is 0.0308 ± 0.0001 g/100 g on day 10 and 0.0304 ± 0.0002 g/100 g on day 20 of storage. The mean D-glucose concentration for the kefir with volatile lavender oil on the first day of storage is 0.0344 ± 0.0002 g/100 g. The mean D-glucose content is 0.0338 ± 0.0001 g/100 g on day 10 of storage and 0.0332 ± 0.0002 g/100 g on day 20. The mean D-glucose concentration for the kefir with volatile oil of mint is 0.0323 ± 0.0001 g/100 g on the first day of storage. The mean is 0.0318 ± 0.0002 g/100 g on day 10 and 0.0313 ± 0.0001 g/100 g on day 20 of storage. The average amount of D-glucose in the kefir sample containing volatile fennel oil on the first day of storage is 0.0315 ± 0.0001 g/100 g. The mean D-glucose content is 0.0312 ± 0.0001 g/100 g on day 10 and 0.0309 ± 0.0001 g/100 g on day 20 of storage.
3.5. Determination of L-Glutamic Acid Content
Table A4 (
Appendix A) presents the results of determining the L-glutamic acid content for each kefir sample, as well as the statistical processing of the obtained data. For each kefir sample, three replicates were performed on each day of analysis.
Figure 6 compares the variations in L-glutamic acid content between the control sample and the samples of cow’s milk kefir that have been enhanced with encapsulated volatile oils.
All of the kefir samples see an increase in L-glutamic acid content during the entire storage period. On the first day of storage, the control sample’s mean level of L-glutamic acid was 0.0113 ± 0.0002 g/100 g. The mean L-glutamic acid concentration is 0.0125 ± 0.0001 g/100 g on day 10 of storage and 0.0157 ± 0.0001 g/100 g on day 20. The mean L-glutamic acid level of the kefir with volatile lavender oil on the first day of storage is 0.0526 ± 0.0001 g/100 g. The mean is 0.0538 ± 0.0001 g/100 g on day 10 and 0.0559 ± 0.0001 g/100 g on day 20 of storage. The mean L-glutamic acid level in the kefir sample containing the volatile oil of mint is 0.0213 ± 0.0002 g/100 g on the first day of storage. The mean is 0.0224 ± 0.0002 g/100 g on day 10 and 0.0231 ± 0.0002 g/100 g on day 20 of storage. The mean L-glutamic acid level on the first day of storage is 0.0661 ± 0.0001 g/100 g for the kefir with volatile fennel oil. The mean is 0.0672 ± 0.0002 g/100 g on the 10th day of storage, and it is 0.0686 ± 0.0001 g/100 g on the 20th day.
3.6. Determination of Acetic Acid Content
Table A5 (
Appendix A) presents the results of determining the acetic acid content for each kefir sample, as well as the statistical processing of the obtained data. For each kefir sample, three replicates were performed on each day of analysis.
Figure 7 compares the variations in acetic acid levels between the control sample and the kefir samples that have been enhanced with encapsulated volatile oils.
The acetic acid content of the kefir samples rises after 20 days of storage. The average amount of acetic acid in the control sample on the first day of storage was 0.0018 ± 0.0001 g/100 g. The mean acetic acid content is 0.0027 ± 0.0001 g/100 g on the 10th day of deposition and 0.0039 ± 0.0001 g/100 g on the 20th day.
The mean of the acetic acid content from the first day of storage for the kefir sample with volatile lavender oil is 0.0003 ± 0.0001 g/100 g. The mean acetic acid content is 0.0006 ± 0.0001 g/100 g on day 20 and 0.0004 ± 0.0001 g/100 g on day 10. The mean acetic acid content of the kefir sample containing the volatile oil of mint is 0.0001 ± 0.0001 g/100 g on the first day of storage. The average acetic acid concentration on day 20 of storage is 0.0005 ± 0.0001 g/100 g. The average amount of acetic acid in the kefir sample containing volatile fennel oil on the first day of storage is 0.0003 ± 0.0001 g/100 g. The mean acetic acid content is 0.0005 ± 0.0001 g/100 g on the 10th day of storage and 0.0007 ± 0.0001 g/100 g on the 20th day.
3.7. Determination of Ethanol Content
Table A6 (
Appendix A) presents the results of determining the ethanol content for each kefir sample, as well as the statistical processing of the obtained data. For each kefir sample, three replicates were performed on each day of analysis.
Figure 8 compares the variations in ethanol content between the control sample and the cow’s milk kefir samples that have been enhanced with encapsulated volatile oils.
All of the examined kefir samples have an increase in ethanol content over the period. The average amount of ethanol in the control sample on the first day of storage was 0.0005 ± 0.0001 g/100 g. The mean ethanol content is 0.0007 ± 0.0001 g/100 g on the 10th day of storage and 0.0010 ± 0.0001 g/100 g on the 20th day.
The mean ethanol concentration from the first day of storage for the sample of kefir with volatile lavender oil is 0.0003 ± 0.0001 g/100 g. The average ethanol content is 0.0005 ± 0.0001 g/100 g on the 10th day of storage and 0.0008 ± 0.0001 g/100 g on the 20th day. The mean of the ethanol concentration from the first day of storage is 0.0003 ± 0.0001 g/100 g in the case of the kefir with volatile mint oil. The ethanol content is 0.0005 ± 0.0001 g/100 g on day 10 and 0.0007 ± 0.0001 g/100 g on day 20 of storage. The mean ethanol concentration of the kefir sample with volatile fennel oil on the first day of storage is 0.0001 ± 0.0001 g/100 g. The mean ethanol content is 0.0002 ± 0.0001 g/100 g on the 10th day of storage and 0.0005 ± 0.0001 g/100 g on the 20th day.
3.8. Determination of L-Lactic Acid Content
Table A7 (
Appendix A) presents the results of determining the ethanol content for each kefir sample, as well as the statistical processing of the obtained data. For each kefir sample, three replicates were performed on each day of analysis.
Figure 9 compares the variations in L-lactic acid content between the control sample and the samples of cow’s milk kefir that have been enhanced with encapsulated volatile oils.
The amount of L-lactic acid increases during the 20-day storage period. The mean L-lactic acid content of the control sample on the first day of storage is 0.7014 ± 0.0001 g/100 g. L-lactic acid content is 0.7028 ± 0.0001 g/100 g on day 10 of storage and 0.7039 ± 0.0001 g/100 g on day 20. The mean of the L-lactic acid content from the first day of storage is 0.7021 ± 0.0001 g/100 g for the kefir sample containing volatile lavender oil. The mean L-lactic acid content is 0.7026 ± 0.0001 g/100 g on day 10 of storage and 0.7029 ± 0.0001 g/100 g on day 20. The mean L-lactic acid level from the first day of storage is 0.7007 ± 0.0001 g/100 g for the kefir sample containing volatile mint oil. The mean L-lactic acid content is 0.7009 ± 0.0001 g/100 g on the 10th day of storage and 0.7011 ± 0.0001 g/100 g on the 20th day. The mean L-lactic acid level of the sample containing volatile fennel oil on the first day of storage is 0.7019 ± 0.0002 g/100 g. The mean is 0.7023 ± 0.0002 g/100 g on day 10 and 0.7025 ± 0.0001 g/100 g on day 20.
4. Discussion
The many components in the plants used in this study contribute to their antibacterial properties. The most important compounds of fennel are trans-anethole and α-pinene [
62]. Trans-anethole has strong antifungal activity by inhibiting the mycelial growth of a wide range of fungi and could be used as a preservative in food preparation and processing [
63,
64]. The tested antimicrobial potential of α-pinene is moderate [
65]. The antimicrobial capacity of volatile fennel oil is also given by compounds such as β-myrcene, eucalyptol [
66], γ-Terpinene [
67,
68], camphor [
69], terpinen-4-ol [
70], and linalool [
71]. γ-Terpinene is a very potent antimicrobial agent against Gram-positive and Gram-negative bacteria [
67], especially
Escherichia coli and
Staphylococcus aureus bacteria [
68]. Lavender volatile oil compounds with antimicrobial character are α-pinene [
65], eucalyptol [
66], nerolidol [
72], p-Cymene [
73], β-caryophyllene, camphor [
69], terpinen-4-ol [
70], linalool [
71], and linalyl acetate [
74]. Studies have shown that nerolidol has potent antibacterial activity against
Staphylococcus aureus [
72]. The antimicrobial character of volatile mint oil is provided by compounds such as α-pinene [
65], β-myrcene, eucalyptol [
66], eugenol [
75,
76], p-Cymene [
73], γ-Terpinene [
67,
68], β-caryophyllene [
69], pulegone [
77], menthone [
78], sabinene [
79], and linalool [
71]. Eugenol has been reported to have high antibacterial activity [
75], inhibiting the growth of several test microorganisms such as
Escherichia coli,
Aeromonas hydrophila, and
Salmonella typhi [
76].
The study aimed to produce a functional dairy product that brings nutritional benefits to the consumer’s health. The use of volatile oils with antimicrobial capacity aims to increase the finished product’s shelf life. The antimicrobial capacity of the volatile oils used was initially tested on several types of microorganisms affecting food products, especially dairy products.
Following the antimicrobial determination, volatile mint oil has the highest antibacterial activity against the chosen microorganisms, with Aspergillus niger being the only microorganism that showed resistance to it. The most sensitive bacteria to this kind of oil include Escherichia coli, Penicillium expansum, and Geotrichum candidum. Escherichia coli is quite susceptible to the antibacterial effects of lavender and fennel volatile oils. The antibacterial activity of volatile lavender oil is low to moderate against Aspergillus niger and intermediate against Geotrichum candidum and Penicillium expansum. The remaining chosen microorganisms are only weakly inhibited by the fennel volatile oil’s antimicrobial properties.
Using encapsulated volatile oils and cow’s milk, we created three different forms of kefir. We analyzed different chemical compounds in kefir using enzymatic methods. Enzyme kits from the R-Biopharm company were used. The analyzed compounds were lactose, D-glucose, D-galactose, acetic acid, ethanol, L-lactic acid, and L-glutamic acid.
The kefir with lavender oil has the highest lactose concentration, while the control sample has the lowest amount. The lactose level, as assessed by the enzymatic method, gradually declines during storage in the case of kefir samples enhanced with volatile oils, especially between days 10 and 20. The lactose concentration of the control sample is lower than that of the kefir samples with oils, and it decreases more quickly throughout storage.
The D-galactose content of the four kefir samples reduces throughout storage. The kefir sample with volatile lavender oil has the highest concentration of D-galactose, while the control sample has the lowest concentration. The loss of D-galactose happens more gradually in kefir samples that contain volatile oils, particularly between the first and tenth days of storage. Over the remaining storage term, the fall gradually quickens. In the case of the control sample, the decline speeds up during the 20-day storage period.
The kefir sample with volatile lavender oil has the highest D-glucose concentration on day 1 of storage, while the control sample has the lowest. On days 10 and 20 of storage, similar outcomes were attained. The D-glucose level of kefir samples with volatile oils falls gradually over the first 10 days of storage in contrast to the subsequent days when this drop significantly accelerates. For the control sample, the decline would happen more quickly during the storage period.
During the 20 days of storage, the L-glutamic acid concentration of the kefir samples rises. The fennel volatile oil kefir sample had higher glutamic acid content than the control sample, which had a lower level. About kefir samples containing volatile oils, the rise in L-glutamic acid concentration is gradual for the first 10 days of storage before increasing rapidly over the next 10. When compared to the control sample, the level of L-glutamic acid rises more quickly throughout storage.
All four samples of kefir had an increase in acetic acid levels due to storage. The control sample had the greatest acetic acid content throughout all three days of examination, whereas the kefir sample with volatile mint oil had the lowest. About kefir samples containing volatile oils, the increase in acetic acid level is slower during the first 10 days of storage than it is for the control sample, which has an accelerated increase throughout the storage period.
The four varieties of kefir all contain more ethanol after 20 days of storage. The kefir sample with volatile fennel oil has the lowest level of ethanol on day 1 of storage, and the control sample has the highest level. The control sample has the greatest ethanol content on days 10 and 20, while the kefir sample with volatile fennel oil has the lowest. Kefir samples containing volatile oils show a slower increase in ethanol level during the first 10 days of storage compared to the last 10 days of storage. The greatest levels of ethanol concentration were found in the control sample, and during the storage period, the growth accelerated at a faster rate.
The kefir sample with volatile lavender oil has the highest value of the L-lactic acid content on the first day of storage, whereas the kefir sample with volatile mint oil has the lowest value. The control sample has the highest L-lactic acid level on days 10 and 20, whereas the kefir sample with volatile mint oil has the lowest. When it comes to kefir samples that contain volatile oils, the increase in L-lactic acid content happens more slowly during the first 10 days of storage than it does during the final days. For the control sample, it happens more quickly, all during storage time.
5. Conclusions
This research aims to develop functional foods enriched with bioactive compounds. The food product that we decided to enrich with bioactive components is cow’s milk kefir. Volatile oils extracted from lavender, mint, and fennel are excellent sources of nutritive compounds, as they have antimicrobial and antioxidant properties. Due to the fact that volatile oils are very sensitive to the action of external factors, they were encapsulated in a natural polymer matrix (sodium alginate). Finally, three types of kefir with volatile oil capsules were obtained, as well as a kefir control sample.
To highlight, on the one hand, the nutritional intake and the influence of bioactive compounds in the finished product and, on the other hand, the advantages of using encapsulation, the enzymatic analysis of several chemical compounds, were used.
The kefir samples enriched with volatile oils obtained superior results compared to the control sample during the whole analysis period.
Encapsulating the volatile oils in the sodium alginate and adding the capsules to kefir resulted in a value-added finished product.
The main advantage of using encapsulation is that the bioactive compounds of the volatile oils are gradually released in the kefir sample due to the protection provided by sodium alginate.
All these aspects show that the obtained products have a high nutritional value, bringing benefits to the health of the consumer. The completed product has a longer shelf life since volatile oils have antibacterial properties.